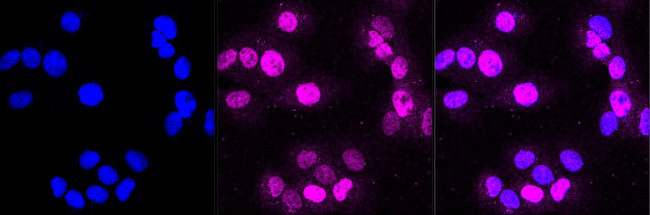
DDB2 Antibody in Immunocytochemistry (ICC/IF)

Search
Invitrogen
DDB2 Recombinant Rabbit Monoclonal Antibody (23GB2805)
{{$productOrderCtrl.translations['antibody.pdp.commerceCard.promotion.promotions']}}
{{$productOrderCtrl.translations['antibody.pdp.commerceCard.promotion.viewpromo']}}
{{$productOrderCtrl.translations['antibody.pdp.commerceCard.promotion.promocode']}}: {{promo.promoCode}} {{promo.promoTitle}} {{promo.promoDescription}}. {{$productOrderCtrl.translations['antibody.pdp.commerceCard.promotion.learnmore']}}
图: 1 / 3
DDB2 Antibody (MA5-53280) in ICC/IF



Please note: We are reviewing Western blot images included in the antibody testing data in our catalog, including those provided by third parties. Unless expressly labeled or annotated as “raw-unedited”, Western blot images included in the antibody testing data in our catalog may have been edited, optimized or otherwise adjusted for presentation.
产品信息
MA5-53280
种属反应
宿主/亚型
Expression System
分类
类型
克隆号
抗原
偶联物
形式
浓度
规格
纯化类型
保存液
内含物
保存条件
运输条件
RRID
靶标信息
Damaged DNA binding protein (DDB) is a heterodimer composed of two subunits, p127 and p48, which are designated DDB1 and DDB2, respectively. The DDB heterodimer is involved in repairing DNA damaged by ultraviolet light. Specifically, DDB, also designated UV-damaged DNA binding protein (UV-DDB), xeroderma pigmentosum group E binding factor (XPE-BF) and hepatitis B virus X-associated protein 1 (XAP-1), binds to damaged cyclobutane pyrimidine dimers (CPDs). Mutations in the DDB2 gene are implicated as causes of xeroderma pigmentosum group E, an autosomal recessive disease in which patients are defective in nucleotide excision DNA repair. XPE is characterized by hypersensitivity of the skin to sunlight with a high frequency of skin cancer as well as neurologic abnormalities. The hepatitis B virus (HBV) X protein interacts with DDB1, which may mediate HBx transactivation.
仅用于科研。不用于诊断过程。未经明确授权不得转售。
篇参考文献 (0)
生物信息学
蛋白别名: Damage-specific DNA-binding protein 2; DDB p48 subunit; DDBb; DNA damage-binding protein 2; UV-damaged DNA-binding protein 2; UV-DDB 2
基因别名: DDB2
Entrez Gene ID: (Human) 1643